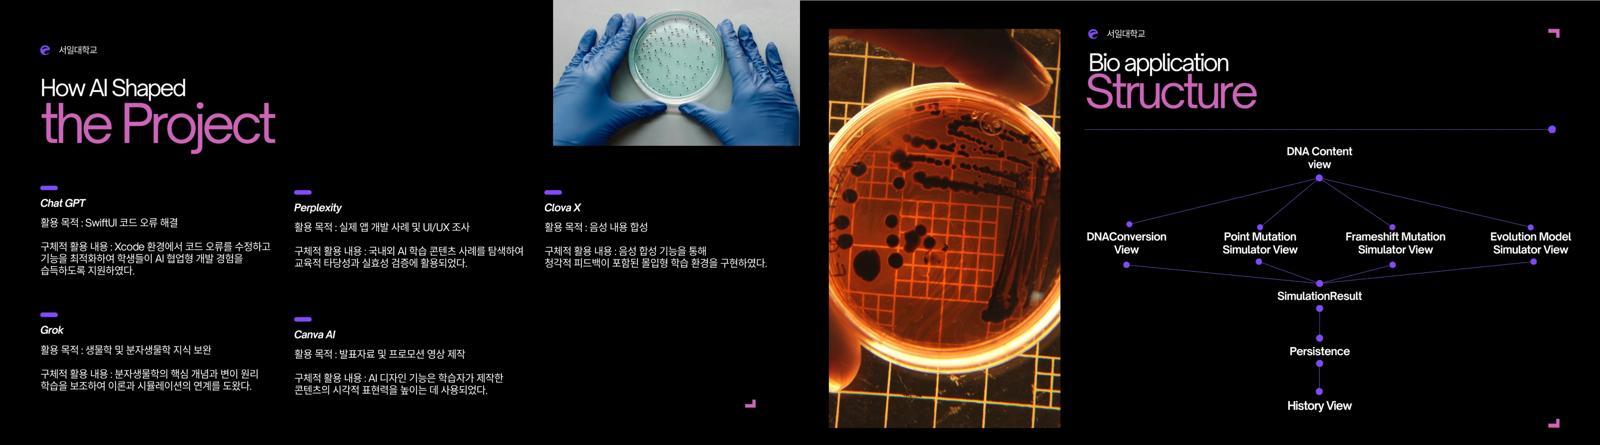
AI 학습 활용 부문 대상작 (서일대학교 AI 활용 분자생물학 교육용 앱 개발)

공유하기
‘전국 전문대학 AI 활용 콘텐츠 공모전’ 성료 …서일대·안산대 대상
- 동아경제
글자크기 설정
전국 혁신지원사업 참여 전문대서 200여개 팀 참가
AI 기반 창작 역량 확산, 전문대 혁신지원사업 성과 입증

전문대학 혁신지원사업 발전협의회에서 주최하고, 교육부와 한국연구재단이 후원한 ‘전국 전문대학 AI 학습활용 콘텐츠 공모전’이 성황리에 마무리됐다.
전국 혁신지원사업 참여 전문대학에서 200여 팀이 참여한 이번 공모전은 학생들이 학교생활과 전공 학습 속에서 AI를 활용해 제작한 콘텐츠를 겨루는 자리로, 전문대 학생들의 창의성과 실무 역량이 돋보였다는 평가를 받았다.
이번 공모전은 정부의 ‘AI 기반 고등교육 혁신’ 기조와 맞물려 전문대학 현장에서의 AI 활용 역량을 실질적으로 강화했다는 점에서 정책적 의미도 크다. 교육부가 추진 중인 ‘AI·디지털 인재 양성 정책’과도 부합하며, 전문대학이 지역산업과 현장 중심 교육에서 AI를 적극적으로 도입하는 사례를 넓혀가는 계기가 됐다.
우수상에는 청강문화산업대학교, 서울예술대학교, 인하공업전문대학교, 영남이공대학교, 충북보건과학대학교 등 총 8팀이 선정됐다. 장려상은 대전과학기술대, 경인여대, 부산보건대, 충청대, 재능대, 서영대, 동아방송예술대, 경남정보대 등 총 15팀이 수상했으며, 간호·치기공학·패션뷰티·영상제작·AI 학과 등 다양한 전공이 고르게 이름을 올렸다.
심사위원단은 작품의 창의성·실용성·완성도·확산성을 중심으로 평가했으며, “학생들이 AI를 단순히 기술로 소비하는 것이 아니라 학습·창작의 파트너로 활용하는 수준까지 도달한 점이 인상적이었다”고 평가했다. 또 다른 심사위원은 “ChatGPT를 활용한 스크립트 작성, Midjourney를 활용한 이미지 생성, Runway를 활용한 영상 자동편집 등 최신 AI 기술을 자연스럽게 접목해 실무적 활용 가능성을 보여주고 있다. 전공과 관계없이 AI 적용 방식이 다양해지고 있으며 전문대 학생들의 실무 역량이 빠르게 성장하고 있다”고 밝혔다.
이번 공모전은 전문대학 혁신지원사업의 목표인 AI 기반 교육혁신·창의융합 인재 양성의 성과를 대외적으로 입증한 사례로 평가받고 있다. 수상작들은 향후 교육자료, 비교과 프로그램, 지역사회 확산 콘텐츠로 적극 활용될 예정이다.
© dongA.com All rights reserved. 무단 전재, 재배포 및 AI학습 이용 금지
트렌드뉴스
-
1
“코 스프레이 2번 뿌렸더니 기억력 쑥”…치매 치료 가능성 [노화설계]
-
2
“꼬마가 이렇게 크다니”…안정환·이혜원 딸 리원, 뉴욕대 졸업
-
3
“언니 따라 갔던 대학”… 네 자매 인생 바꾼 서정대의 배움
-
4
‘미남 농구스타’ 우지원·전희철 딸들, 나란히 미스코리아 본선
-
5
반도체로 부유해진 대만 경제의 그림자: 대만병과 거지 슈퍼맨 [딥다이브]
-
6
박명수 “사람 하나 잘못 뽑으면 어떤 꼴 났는지 아시지 않나”
-
7
소유 “10년전 1억 넣은 삼전·하닉 덕에 내집 마련”
-
8
아픈 딸 둔 아빠에게 ‘2500원 중고차’ 넘긴 김선태…트렁크에 ‘깜짝 선물’까지
-
9
안정환 딸 리원, 뉴욕대 졸업…이혜원 “자랑스러워”
-
10
이란 “고농축 우라늄 국외 반출 없다”…미국 요구 거부
-
1
李, 기표한 투표지 들고나와 “반만 찍혔는데 괜찮나”
-
2
李대통령 “투표 포기, ‘중립’ 아닌 ‘그들’ 편드는 것”
-
3
홍준표 “투표함 관리 철저하면 부정선거 시비 사라져”
-
4
美 “韓 핵잠 도입, 적국엔 딜레마…작전통제권 주도 고무적”
-
5
국힘, ‘기표소 논란’ 李 선거법 위반 혐의 고발
-
6
與 “해프닝인데 억지” vs 野 “李, 특권 과시”…기표소 논란 이틀째 공방
-
7
반도체로 부유해진 대만 경제의 그림자: 대만병과 거지 슈퍼맨 [딥다이브]
-
8
홍명보 “정몽규 사의 굉장히 당황스럽다”
-
9
사전투표율 23.51% 역대 지선 최고…1050만명 선택 마쳤다
-
10
광주시장 “스타벅스, 전국 매장 문닫고 직원 교육한 美 본받아라”
트렌드뉴스
-
1
“코 스프레이 2번 뿌렸더니 기억력 쑥”…치매 치료 가능성 [노화설계]
-
2
“꼬마가 이렇게 크다니”…안정환·이혜원 딸 리원, 뉴욕대 졸업
-
3
“언니 따라 갔던 대학”… 네 자매 인생 바꾼 서정대의 배움
-
4
‘미남 농구스타’ 우지원·전희철 딸들, 나란히 미스코리아 본선
-
5
반도체로 부유해진 대만 경제의 그림자: 대만병과 거지 슈퍼맨 [딥다이브]
-
6
박명수 “사람 하나 잘못 뽑으면 어떤 꼴 났는지 아시지 않나”
-
7
소유 “10년전 1억 넣은 삼전·하닉 덕에 내집 마련”
-
8
아픈 딸 둔 아빠에게 ‘2500원 중고차’ 넘긴 김선태…트렁크에 ‘깜짝 선물’까지
-
9
안정환 딸 리원, 뉴욕대 졸업…이혜원 “자랑스러워”
-
10
이란 “고농축 우라늄 국외 반출 없다”…미국 요구 거부
-
1
李, 기표한 투표지 들고나와 “반만 찍혔는데 괜찮나”
-
2
李대통령 “투표 포기, ‘중립’ 아닌 ‘그들’ 편드는 것”
-
3
홍준표 “투표함 관리 철저하면 부정선거 시비 사라져”
-
4
美 “韓 핵잠 도입, 적국엔 딜레마…작전통제권 주도 고무적”
-
5
국힘, ‘기표소 논란’ 李 선거법 위반 혐의 고발
-
6
與 “해프닝인데 억지” vs 野 “李, 특권 과시”…기표소 논란 이틀째 공방
-
7
반도체로 부유해진 대만 경제의 그림자: 대만병과 거지 슈퍼맨 [딥다이브]
-
8
홍명보 “정몽규 사의 굉장히 당황스럽다”
-
9
사전투표율 23.51% 역대 지선 최고…1050만명 선택 마쳤다
-
10
광주시장 “스타벅스, 전국 매장 문닫고 직원 교육한 美 본받아라”
-
- 좋아요
- 0개
-
- 슬퍼요
- 0개
-
- 화나요
- 0개



댓글 0